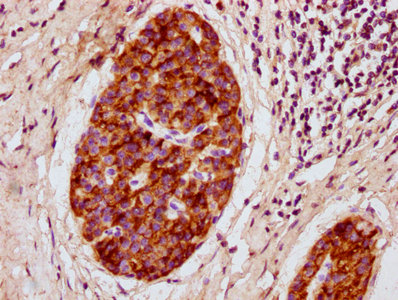

-
中文名稱:Prl兔多克隆抗體
-
貨號:CSB-PA018724LA01RA
-
規(guī)格:¥440
-
圖片:
-
IHC image of CSB-PA018724LA01RA diluted at 1:300 and staining in paraffin-embedded human pancreatic cancer performed on a Leica BondTM system. After dewaxing and hydration, antigen retrieval was mediated by high pressure in a citrate buffer (pH 6.0). Section was blocked with 10% normal goat serum 30min at RT. Then primary antibody (1% BSA) was incubated at 4°C overnight. The primary is detected by a biotinylated secondary antibody and visualized using an HRP conjugated SP system.
-
-
其他:
產(chǎn)品詳情
-
產(chǎn)品名稱:Rabbit anti-Rattus norvegicus (Rat) Prl Polyclonal antibody
-
Uniprot No.:
-
基因名:
-
別名:Prl antibody; Prolactin antibody; PRL antibody
-
宿主:Rabbit
-
反應(yīng)種屬:Rat
-
免疫原:Recombinant Rat Prolactin protein (30-226AA)
-
免疫原種屬:Rattus norvegicus (Rat)
-
標記方式:Non-conjugated
本頁面中的產(chǎn)品,Prl Antibody (CSB-PA018724LA01RA),的標記方式是Non-conjugated。對于Prl Antibody,我們還提供其他標記。見下表:
-
克隆類型:Polyclonal
-
抗體亞型:IgG
-
純化方式:>95%, Protein G purified
-
濃度:It differs from different batches. Please contact us to confirm it.
-
保存緩沖液:Preservative: 0.03% Proclin 300
Constituents: 50% Glycerol, 0.01M PBS, pH 7.4 -
產(chǎn)品提供形式:Liquid
-
應(yīng)用范圍:ELISA, IHC
-
推薦稀釋比:
Application Recommended Dilution IHC 1:200-1:500 -
Protocols:
-
儲存條件:Upon receipt, store at -20°C or -80°C. Avoid repeated freeze.
-
貨期:Basically, we can dispatch the products out in 1-3 working days after receiving your orders. Delivery time maybe differs from different purchasing way or location, please kindly consult your local distributors for specific delivery time.
-
用途:For Research Use Only. Not for use in diagnostic or therapeutic procedures.
相關(guān)產(chǎn)品
靶點詳情
-
功能:Prolactin acts primarily on the mammary gland by promoting lactation.
-
基因功能參考文獻:
- It was examined whether prolactin modulation alters ventral prostate (VP) morphophysiology in adult castrated rats. PMID: 28988314
- Data suggest that prolactin and oleic acid synergistically stimulate beta-cell proliferation and islet growth; in cultured neonatal islets, prolactin increases cell proliferation 6-fold, oleic acid 3.5-fold, and their combination 15-fold. Similar results were observed in cultured adult islets. PMID: 28686504
- Involvement of prolactin in the regulation of bicarbonate biodynamics using female rat model of cholestasis of pregnancy. PMID: 28361424
- This study reports on the effect of copulation on potentially precancerous prostate lesions, serum testosterone and prolactin levels in rats. PMID: 27356573
- This study demonstrated that the Cultured neurons expressed mRNA for both PRL and its receptor (PRLR), and both PRL and PRLR expression levels changed after the excitotoxic insult. PMID: 26874070
- Data confirm that prolactin secretion by anterior pituitary gland can be down-regulated by environmental endocrine disruptors; here, perfluorooctane sulfonate affects periventricular-hypophysial dopaminergic neurons in mechanism involving estradiol. PMID: 26032630
- In conclusion, PRL was responsible for the lactation-induced mucosal adaptations, which were associated with compensatory increase in FGF-23 expression probably to prevent calcium hyperabsorption. PMID: 26657069
- PRL is unchanged in a rat model of panic evoked by dorsal periaqueductal gray stimulation. PMID: 25618592
- Prolactin actively supports lactation providing amino acids to the gland through SNAT2 for the synthesis of milk proteins. PMID: 25701231
- Results showed that an active sexual life, with constant execution of sexual behavior, produces a sustained increase in serum PRL, prostate PRL receptors, and the pStat3 signaling pathway PMID: 25446202
- This study showe that TGF-beta and TNF-alpha antagonize the effect of each other on the expression and release of prolactin in a cell line and in obese and diabetic rats. PMID: 25715833
- supraphysiological levels of PRL affect carcinogenesis. PL induces regression of the tumors due to the differentiation produced on the mammary cells. PMID: 25136563
- Prolactin induces apoptosis of lactotropes PMID: 24859278
- High Prolactin expression is associated with Streptozotocin diabetes. PMID: 24984282
- insulin activates prolactin gene transcription by activating Elk-1 that recruits the NuA4 complex to the promoter. PMID: 24075908
- PRL acts on ARC neurons to inhibit kisspeptin expression in female rats PMID: 24456164
- serum levels may be involved in the homing events to mammary glands, probably helping antibody-secreting cells and protecting the gland during lactation development PMID: 23904563
- Prolactin inhibits apoptosis in chondrocytes in response to a mixture of proinflammatory cytokines. PMID: 23908112
- Our data confirmed the regulatory role of dopamine, serotonin, and TRH on PRL secretion, however, the interaction between these and glutamatergic systems was not confirmed. PMID: 23641787
- Data from 2 hepatic insufficiency models suggest that pituitary expression of Prl and estrogen receptor alpha is up-regulated in this state, positively correlating with increase in serum 17beta-estradiol level; data show gastro-hepato-pituitary axis. PMID: 22843122
- The results indicate that under prolonged duration of a daily melatonin signal, rat anterior pituitary prolactin synthesis and release are depressed, together with significant changes in the redox and circadian mechanisms controlling them. PMID: 22891630
- results show that the effect of centrally injected allopreganolone over reproductive function could be due to a centrally originated LH mediated effect over ovarian function that affects luteal regression, through the inhibition of apoptosis and stimulation of progesterone and prolactin release PMID: 22674474
- Lactotroph nonselective cation channels, presumably belonging to the TRPC family, contribute to the background depolarizing conductance and firing of action potentials with consequent prolactin release. PMID: 22480423
- Data suggest that the resolution of an inflammatory response is associated with dramatic activation of the prolactin (PRL) gene promoter in the myeloid lineage. PMID: 22495675
- E(2) may act as a modulator of the prolactin secretory response induced by TRH through membrane estrogen receptors, with the contribution by PI3K/Akt pathway activation. PMID: 22354782
- The results show that PRL expression and cell proliferation are controlled in part by CEBPD. PMID: 21980073
- Gonadotrophs are the major source of Nrg1 in the normal anterior pituitary and Nrg1 may function as a paracrine/juxtacrine regulator of PRL secretion. PMID: 21919974
- Data suggest that prolactin is involved in regulation of prolactin receptor expression and maintenance of physiological cell renewal in anterior pituitary. PMID: 22094470
- Data suggest that inflammation leads to accumulation of endogenous prolactin in female and male rats, and that prolactin acts as an inflammatory mediator at different time points for female and intact male rats. PMID: 21777304
- Prolactin inhibition during late lactation programs renal function damage in adult offspring. PMID: 21823059
- Estradiol regulates dopamine-activataed GIRK channel activity in pituitary lactotrophs, regulating prolactin release during the estrous cycle. PMID: 21653876
- Integrity of the pelvic nerve is necessary for the systemic oxytocin induction of the PRL secretory rhythm in ovariectomized rats. PMID: 21677274
- NONO and SFPQ were functionally involved in circadian Prl transcription since overexpression of both proteins greatly reduced Prl promoter activity (P<0.001) and disrupted its circadian pattern. PMID: 21507896
- The anterior pituitary production of 16 kDa prolactin is variable along the estrous cycle and increased by estrogens. PMID: 21760910
- Complex interactions between Ahr and Esr alter Prl and luteinizing hormone (LH) synthesis by direct actions in lactotropes and gonadotropes. PMID: 21187122
- Results suggest that bone morphogenetic proteins elicit differential actions in the regulation of prolactin release dependent on cellular cAMP-PKA activity. PMID: 20970474
- PREB can function as a transcriptional regulator of PRL promoter activity and might be involved in TRH-induced PRL gene transcription PMID: 20960102
- Results suggest a role for dopamine in the generation of the oestrous prolactin surge. PMID: 20722974
- Prolactin diminishes the damaging actions of excitotoxicity in the kainate model of epilepsy. PMID: 20570717
- Data show that inactivation of tyrosine hydroxylase in hypothalamic neuroendocrine dopamine neurons is required for suckling-induced prolactin and ACTH responses. PMID: 20170714
- Results demonstrate clearly that certain circadian elements binding to the E-box133 site are required for episodes of PRL mRNA expression. PMID: 20215567
- Prolactin gene expression data suggest that pituitary tissue comprises a series of cell ensembles, which individually display a variety of patterns of short-term stochastic behaviour, but together yield long-range and long-term coordinated behaviour. PMID: 20130141
- results indicate that specific effects upon male rat lactotropes may be exerted by PRL variants released from anterior pituitary glands of lactating and non-lactating rats PMID: 19590175
- At 5 h after progesterone (P(4)) treatment, tyrosine hydroxylase activity and phosphorylation state declined coincident with an increase in plasma prolactin in both P(4)-treated morning and afternoon groups. PMID: 19945993
- PRL directly enhanced the transcellular and paracellular calcium transport in the rat cecum through the nongenomic signaling pathways involving PI3K, PKC, and ROCK. PMID: 19449156
- Review: evidence demonstrating PRL synthesis by different subtypes of immune cells from humans, mice and rats, describe the regulation of PRL gene expression in human lymphocytes, and discuss the functions of PRL made by immune cells. PMID: 11721692
- Review: Effects of prolactin on signal transduction and gene expression: possible relevance for systemic lupus erythematosus. PMID: 11721698
- Review: effects of changing the ratio of these two forms in maternal PRL on gamma delta T cell development in rat pups in utero PMID: 11721700
- physiological prolactin secretion response to stress depends on the renin--angiotensin system PMID: 11888852
- Inverse control of prolactin and growth hormone gene expression: effect of thyroliberin on transcription and RNA stabilization. PMID: 11892801
顯示更多
收起更多
-
亞細胞定位:Secreted.
-
蛋白家族:Somatotropin/prolactin family
-
數(shù)據(jù)庫鏈接:
Most popular with customers
-
-
Phospho-YAP1 (S127) Recombinant Monoclonal Antibody
Applications: ELISA, WB, IHC
Species Reactivity: Human
-
-
-
-
-
-